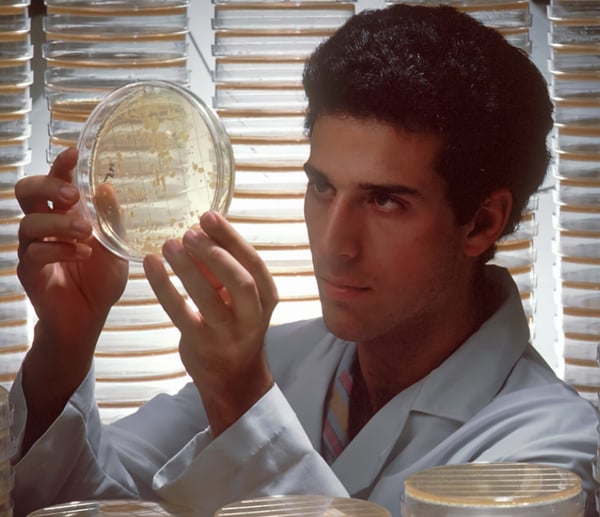

School Blog
Jonathan Harmon
My name is Jonathan and I am the Science Coordinator at RLS. I want all kids to fall in love with science and bring about a rewarding scientific learning experience to all students.
Disgusting Science for Kids
Remember the slime craze, when kids were obsessed with slime-making? Even if many of us occasionally find humor in icky situations, for most, a true fascination with yucky stuff is very much a part of growing up, left behind when we enter the adult world.But ...